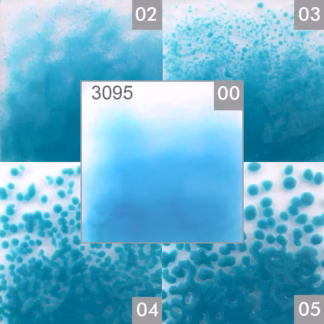
Tojáshéj akvamarin opál 3095 COE 82

Kiegészítők
1–12 termék, összesen 52 db
-

Aventurin barna frit finom 0-0,8 mm
1 520 Ft Kosárba teszem -

Aventurin kék frit finom 0-0,8 mm
2 055 Ft Kosárba teszem -

Float Stringer citromsárga félopál 2035 COE 82
2 951 Ft Opciók választása Ennek a terméknek több variációja van. A változatok a termékoldalon választhatók ki -

Float Stringer cseresznyepiros átlátszó 1045 COE 82
4 304 Ft Opciók választása Ennek a terméknek több variációja van. A változatok a termékoldalon választhatók ki -

Float Stringer fehér opál 3120 COE 82
3 684 Ft Opciók választása Ennek a terméknek több variációja van. A változatok a termékoldalon választhatók ki -

Float Stringer kobaltkék átlátszó 0055 COE 82
2 885 Ft Opciók választása Ennek a terméknek több variációja van. A változatok a termékoldalon választhatók ki -

Float Stringer narancs félopál 2025 COE 82
3 135 Ft Opciók választása Ennek a terméknek több variációja van. A változatok a termékoldalon választhatók ki -

Float Stringer sárga átlátszó 1035 COE 82
3 090 Ft Opciók választása Ennek a terméknek több variációja van. A változatok a termékoldalon választhatók ki -

Float Stringer vegyes színek, 1,2 mm-es COE 82
5 007 Ft Opciók választása Ennek a terméknek több variációja van. A változatok a termékoldalon választhatók ki -

Tojáshéj akvamarin kék átlátszó 0096 COE 82
2 924 Ft Opciók választása Ennek a terméknek több variációja van. A változatok a termékoldalon választhatók ki -
Tojáshéj akvamarin opál 3095 COE 82
2 692 Ft Opciók választása Ennek a terméknek több variációja van. A változatok a termékoldalon választhatók ki -

Tojáshéj aventurinzöld 4045 COE 82
2 895 Ft Opciók választása Ennek a terméknek több variációja van. A változatok a termékoldalon választhatók ki
1–12 termék, összesen 52 db
